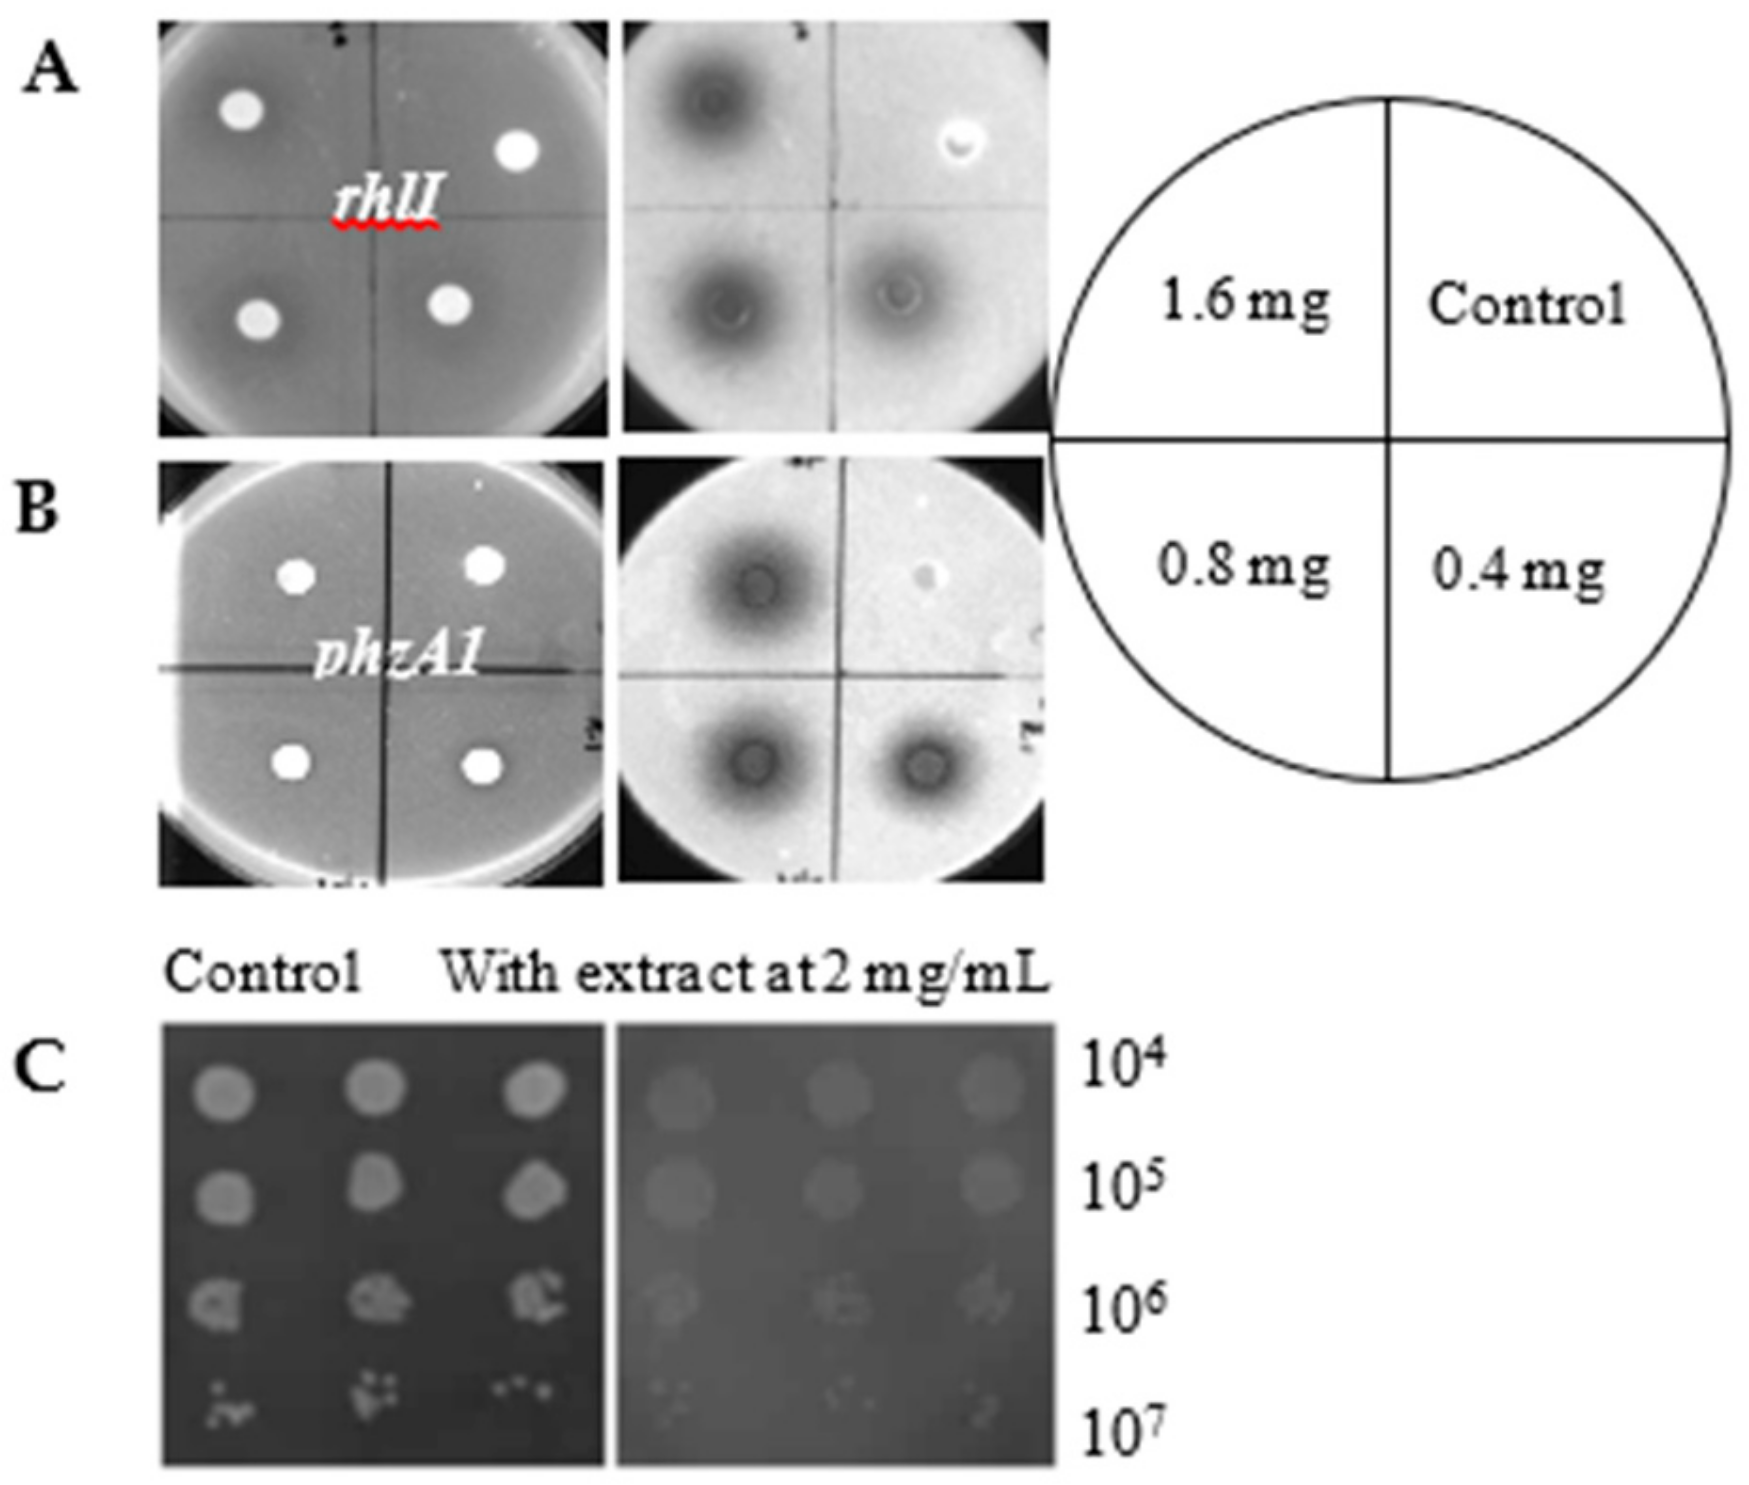
Antibiotics 09 00136 g001

Virulence-Inhibiting Herbal Compound Falcarindiol Significantly Reduced Mortality in Mice Infected with Pseudomonas aeruginosa
Abstract
1. Introduction
2. Results and Discussion
2.1. The Effect of Crude Extract of Notopterygium Incisum Ting ex H. T. Chang on Virulence Factors in P. aeruginosa
2.2. Inhibition of Virulence-Associated Genes in P. aeruginosa and Phenotypes by Falcarindiol
2.3. Falcarindiol Attenuates the Pathogenicity of P. aeruginosa PAO1 in a Burned Mouse Model
3. Materials and Methods
3.1. Bacterial Strains and Culture Conditions
3.2. Herbal Compound Crude Extraction
3.3. Expression Monitoring and Screening for Antipathogenics
3.4. CFU Counting Using the Drop Plate Method
3.5. Drosophila Melanogaster Infection Assay
3.6. Measurement of Pyocyanin Production
3.7. Swarming Motility Assays
3.8. Animal Studies using a Burned Mouse Model
3.9. Statistical Analysis
4. Conclusions
Author Contributions
Funding
Acknowledgments
Conflicts of Interest
References
- Brown, E.D.; Wright, G.D. Antibacterial drug discovery in the resistance era. Nature 2016, 529, 336–343. [Google Scholar] [CrossRef] [PubMed]
- Hentzer, M.; Wu, H.; Andersen, J.B.; Riedel, K.; Rasmussen, T.B.; Bagge, N.; Kumar, N.; Schembri, M.A.; Song, Z.; Kristoffersen, P.; et al. Attenuation of Pseudomonas aeruginosa virulence by quorum sensing inhibitors. EMBO J. 2003, 22, 3803–3815. [Google Scholar] [CrossRef] [PubMed]
- Pearson, J.P.; Feldman, M.; Iglewski, B.H.; Prince, A. Pseudomonas aeruginosa cell-to-cell signaling is required for virulence in a model of acute pulmonary infection. Infect. Immun. 2000, 68, 4331–4334. [Google Scholar] [CrossRef] [PubMed]
- Rumbaugh, K.P.; Griswold, J.A.; Iglewski, B.H.; Hamood, A.N. Contribution of quorum sensing to the virulence of Pseudomonas aeruginosa in burn wound infections. Infect. Immun. 1999, 67, 5854–5862. [Google Scholar] [CrossRef]
- Pirhonen, M.; Flego, D.; Heikinheimo, R.; Palva, E.T. A small diffusible signal molecule is responsible for the global control of virulence and exoenzyme production in the plant pathogen Erwinia carotovora. EMBO J. 1993, 12, 2467–2476. [Google Scholar] [CrossRef]
- Veesenmeyer, J.L.; Hauser, A.R.; Lisboa, T.; Rello, J. Pseudomonas aeruginosa virulence and therapy: Evolving translational strategies. Crit. Care Med. 2009, 37, 1777–1786. [Google Scholar] [CrossRef]
- Coburn, B.; Sekirov, I.; Finlay, B.B. Type III secretion systems and disease. Clin. Microbiol. Rev. 2007, 20, 535–549. [Google Scholar] [CrossRef]
- Hauser, A.R. The type III secretion system of Pseudomonas aeruginosa: Infection by injection. Nat. Rev. Microbiol. 2009, 7, 654–665. [Google Scholar] [CrossRef]
- Schulert, G.S.; Feltman, H.; Rabin, S.D.P.; Martin, C.G.; Battle, S.E.; Rello, J.; Hauser, A.R. Secretion of the toxin ExoU is a marker for highly virulent Pseudomonas aeruginosa isolates obtained from patients with hospital-acquired pneumonia. J. Infect. Dis. 2003, 188, 1695–1706. [Google Scholar] [CrossRef]
- Bhagirath, A.Y.; Somayajula, D.; Li, Y.; Duan, K. CmpX affects virulence in Pseudomonas aeruginosa through the Gac/Rsm signaling pathway and by modulating c-di-GMP levels. J. Membr. Biol. 2017. [Google Scholar] [CrossRef]
- Bleves, S.; Soscia, C.; Nogueiraorlandi, P.; Lazdunski, A.; Filloux, A. Quorum sensing negatively controls type III secretion regulon expression in Pseudomonas aeruginosa PAO1. J. Bacteriol. 2005, 187, 3898–3902. [Google Scholar] [CrossRef] [PubMed]
- Brencic, A.; Mcfarland, K.A.; Mcmanus, H.R.; Castang, S.; Mogno, I.; Dove, S.L.; Lory, S. The GacS/GacA signal transduction system of Pseudomonas aeruginosa acts exclusively through its control over the transcription of the RsmY and RsmZ regulatory small RNAs. Mol. Microbiol. 2009, 73, 434–445. [Google Scholar] [CrossRef] [PubMed]
- Fuqua, C.; Parsek, M.R.; Greenberg, E.P. Regulation of gene expression by cell-to-cell communication: Acyl-homoserine lactone quorum sensing. Annu. Rev. Genet. 2001, 35, 439–468. [Google Scholar] [CrossRef]
- Diggle, S.P.; Cornelis, P.; Williams, P.; Camara, M. 4-quinolone signalling in Pseudomonas aeruginosa: Old molecules, new perspectives. Int. J. Med. Microbiol. 2006, 296, 83–91. [Google Scholar] [CrossRef] [PubMed]
- Williams, P.; Winzer, K.; Chan, W.C.; Camara, M. Look who’s talking: Communication and quorum sensing in the bacterial world. Philos. Trans. R. Soc. Lond. B Biol. Sci. 2007, 362, 1119–1134. [Google Scholar] [CrossRef] [PubMed]
- Defoirdt, T. Quorum-sensing systems as targets for antivirulence therapy. Trends Microbiol. 2018, 26, 313–328. [Google Scholar] [CrossRef]
- Piewngam, P.; Zheng, Y.; Nguyen, T.H.; Dickey, S.W.; Joo, H.S.; Villaruz, A.E.; Glose, K.A.; Fisher, E.L.; Hunt, R.L.; Li, B.; et al. Pathogen elimination by probiotic Bacillus via signalling interference. Nature 2018, 562, 532–537. [Google Scholar] [CrossRef]
- Egan, M.E.; Pearson, M.; Weiner, S.A.; Rajendran, V.; Rubin, D.; Glockner-Pagel, J.; Canny, S.; Du, K.; Lukacs, G.L.; Caplan, M.J. Curcumin, a major constituent of turmeric, corrects cystic fibrosis defects. Science 2004, 304, 600–602. [Google Scholar] [CrossRef]
- Shen, Z.X.; Chen, G.Q.; Ni, J.H.; Li, X.S.; Xiong, S.M.; Qiu, Q.Y.; Zhu, J.; Tang, W.; Sun, G.L.; Yang, K.Q.; et al. Use of arsenic trioxide (As2O3) in the treatment of acute promyelocytic leukemia (APL): II. Clinical efficacy and pharmacokinetics in relapsed patients. Blood 1997, 89, 3354–3360. [Google Scholar] [CrossRef]
- Brown, J.P. A review of the genetic effects of naturally occurring flavonoids, anthraquinones and related compounds. Mutat. Res. 1980, 75, 243–277. [Google Scholar] [CrossRef]
- Qiao, G. Investigation of Virulence Inhibitors and the Quinolone Signal Mediated Regulatory System in Pseudomonas aeruginosa. Ph.D. Thesis, Northwest University, Xi’an, China, 2013. [Google Scholar]
- Duan, K.; Dammel, C.; Stein, J.; Rabin, H.; Surette, M.G. Modulation of Pseudomonas aeruginosa gene expression by host microflora through interspecies communication. Mol. Microbiol. 2003, 50, 1477–1491. [Google Scholar] [CrossRef]
- Guo, Q.; Wu, Q.; Bai, D.; Liu, Y.; Chen, L.; Jin, S.; Wu, Y.; Duan, K. Potential Use of Dimethyl Sulfoxide in Treatment of Infections Caused by Pseudomonas aeruginosa. Antimicrob. Agents Chemother. 2016, 60, 7159–7169. [Google Scholar] [CrossRef] [PubMed]
- Duan, K.; Surette, M.G. Environmental regulation of Pseudomonas aeruginosa PAO1 Las and Rhl quorum-sensing systems. J. Bacteriol. 2007, 189, 4827–4836. [Google Scholar] [CrossRef] [PubMed]
- Kong, W.; Chen, L.; Zhao, J.; Shen, T.; Surette, M.G.; Shen, L.; Duan, K. Hybrid sensor kinase PA1611 in Pseudomonas aeruginosa regulates transitions between acute and chronic infection through direct interaction with RetS. Mol. Microbiol. 2013, 88, 784–797. [Google Scholar] [CrossRef] [PubMed]
- Brint, J.M.; Ohman, D.E. Synthesis of multiple exoproducts in Pseudomonas aeruginosa is under the control of RhlR-RhlI, another set of regulators in strain PAO1 with homology to the autoinducer-responsive LuxR-LuxI family. J. Bacteriol. 1995, 177, 7155–7163. [Google Scholar] [CrossRef]
- Hoang, T.T.; Karkhoff-Schweizer, R.R.; Kutchma, A.J.; Schweizer, H.P. A broad-host-range Flp-FRT recombination system for site-specific excision of chromosomally-located DNA sequences: Application for isolation of unmarked Pseudomonas aeruginosa mutants. Gene 1998, 212, 77–86. [Google Scholar] [CrossRef]
- Mulcahy, H.; Sibley, C.D.; Surette, M.G.; Lewenza, S. Drosophila melanogaster as an animal model for the study of Pseudomonas aeruginosa biofilm infections in vivo. PLoS Pathog 2011, 7, e1002299. [Google Scholar] [CrossRef]
- Luo, J.; Dong, B.; Wang, K.; Cai, S.; Liu, T.; Cheng, X.; Lei, D.; Chen, Y.; Li, Y.; Kong, J.; et al. Baicalin inhibits biofilm formation, attenuates the quorum sensing-controlled virulence and enhances Pseudomonas aeruginosa clearance in a mouse peritoneal implant infection model. PLoS ONE 2017, 12, e0176883. [Google Scholar] [CrossRef]
- Ouyang, J.; Sun, F.; Feng, W.; Sun, Y.; Qiu, X.; Xiong, L.; Liu, Y.; Chen, Y. Quercetin is an effective inhibitor of quorum sensing, biofilm formation and virulence factors in Pseudomonas aeruginosa. J. Appl. Microbiol. 2016, 120, 966–974. [Google Scholar] [CrossRef]
- Zhang, A.; Chu, W.H. Anti-Quorum Sensing Activity of Forsythia suspense on Chromobacterium violaceum and Pseudomonas aeruginosa. Pharmacogn. Mag. 2017, 13, 321–325. [Google Scholar] [CrossRef]
- Zschocke, S.; Lehner, M.; Bauer, R. 5-Lipoxygenase and cyclooxygenase inhibitory active constituents from Qianghuo (Notopterygium incisum). Planta Med. 1997, 63, 203–206. [Google Scholar] [CrossRef] [PubMed]
- Garrod, B.; Lewis, B.G.; Coxon, D.T. Cis-Heptadeca-1,9-diene-4,6-diyne-3,8-diol, an antifungal polyacetylene from carrot root tissue. Physiol. Plant Pathol. 1978, 13, 241–246. [Google Scholar] [CrossRef]
- Zidorn, C.; Johrer, K.; Ganzera, M.; Schubert, B.; Sigmund, E.M.; Mader, J.; Greil, R.; Ellmerer, E.P.; Stuppner, H. Polyacetylenes from the Apiaceae vegetables carrot, celery, fennel, parsley, and parsnip and their cytotoxic activities. J. Agric. Food Chem. 2005, 53, 2518–2523. [Google Scholar] [CrossRef] [PubMed]
- Delaney, S.M.; Mavrodi, D.V.; Bonsall, R.F.; Thomashow, L.S. phzO, a gene for biosynthesis of 2-hydroxylated phenazine compounds in Pseudomonas aureofaciens 30–84. J. Bacteriol. 2001, 183, 318–327. [Google Scholar] [CrossRef] [PubMed][Green Version]
- Clatworthy, A.E.; Pierson, E.; Hung, D.T. Targeting virulence: A new paradigm for antimicrobial therapy. Nat. Chem. Biol. 2007, 3, 541–548. [Google Scholar] [CrossRef] [PubMed]
- Lee, V.T.; Pukatzki, S.; Sato, H.; Kikawada, E.; Kazimirova, A.A.; Huang, J.; Li, X.; Arm, J.P.; Frank, D.W.; Lory, S. Pseudolipasin A is a specific inhibitor for phospholipase A2 activity of Pseudomonas aeruginosa cytotoxin ExoU. Infect. Immun. 2007, 75, 1089–1098. [Google Scholar] [CrossRef] [PubMed]
- Arnoldo, A.; Curak, J.; Kittanakom, S.; Chevelev, I.; Lee, V.T.; Sahebol-Amri, M.; Koscik, B.; Ljuma, L.; Roy, P.J.; Bedalov, A.; et al. Identification of small molecule inhibitors of Pseudomonas aeruginosa exoenzyme S using a yeast phenotypic screen. PLoS Genet. 2008, 4, e1000005. [Google Scholar] [CrossRef]
- Aiello, D.; Williams, J.D.; Majgier-Baranowska, H.; Patel, I.; Peet, N.P.; Huang, J.; Lory, S.; Bowlin, T.L.; Moir, D.T. Discovery and characterization of inhibitors of Pseudomonas aeruginosa type III secretion. Antimicrob. Agents Chemother. 2010, 54, 1988–1999. [Google Scholar] [CrossRef]
- Givskov, M.; de Nys, R.; Manefield, M.; Gram, L.; Maximilien, R.; Eberl, L.; Molin, S.; Steinberg, P.D.; Kjelleberg, S. Eukaryotic interference with homoserine lactone-mediated prokaryotic signalling. J. Bacteriol. 1996, 178, 6618–6622. [Google Scholar] [CrossRef]
- Wu, H.; Song, Z.; Hentzer, M.; Andersen, J.B.; Molin, S.; Givskov, M.; Hoiby, N. Synthetic furanones inhibit quorum-sensing and enhance bacterial clearance in Pseudomonas aeruginosa lung infection in mice. J. Antimicrob. Chemother. 2004, 53, 1054–1061. [Google Scholar] [CrossRef]
- Rasmussen, T.B.; Skindersoe, M.E.; Bjarnsholt, T.; Phipps, R.K.; Christensen, K.B.; Jensen, P.O.; Andersen, J.B.; Koch, B.; Larsen, T.O.; Hentzer, M.; et al. Identity and effects of quorum-sensing inhibitors produced by Penicillium species. Microbiology 2005, 151, 1325–1340. [Google Scholar] [CrossRef] [PubMed]
- Vattem, D.A.; Mihalik, K.; Crixell, S.H.; McLean, R.J. Dietary phytochemicals as quorum sensing inhibitors. Fitoterapia 2007, 78, 302–310. [Google Scholar] [CrossRef] [PubMed]
- Koh, K.H.; Tham, F.Y. Screening of traditional Chinese medicinal plants for quorum-sensing inhibitors activity. J. Microbiol. Immunol. Infect. 2011, 44, 144–148. [Google Scholar] [CrossRef] [PubMed]
- Teplitski, M.; Robinson, J.B.; Bauer, W.D. Plants secrete substances that mimic bacterial N-acyl homoserine lactone signal activities and affect population density-dependent behaviors in associated bacteria. Mol. Plant-Microbe Interact. 2000, 13, 637–648. [Google Scholar] [CrossRef]
- Sawa, T.; Ohara, M.; Kurahashi, K.; Twining, S.S.; Frank, D.W.; Doroques, D.B.; Long, T.; Gropper, M.A.; Wiener-Kronish, J.P. In vitro cellular toxicity predicts Pseudomonas aeruginosa virulence in lung infections. Infect. Immun. 1998, 66, 3242–3249. [Google Scholar] [CrossRef]
- Sawa, T.; Yahr, T.L.; Ohara, M.; Kurahashi, K.; Gropper, M.A.; Wiener-Kronish, J.P.; Frank, D.W. Active and passive immunization with the Pseudomonas V antigen protects against type III intoxication and lung injury. Nat. Med. 1999, 5, 392–398. [Google Scholar] [CrossRef]
- Holder, I.A.; Neely, A.N.; Frank, D.W. PcrV immunization enhances survival of burned Pseudomonas aeruginosa-infected mice. Infect. Immun. 2001, 69, 5908–5910. [Google Scholar] [CrossRef]
- Yamazaki, A.; Li, J.; Zeng, Q.; Khokhani, D.; Hutchins, W.C.; Yost, A.C.; Biddle, E.; Toone, E.J.; Chen, X.; Yang, C.H. Derivatives of plant phenolic compound affect the type III secretion system of Pseudomonas aeruginosa via a GacS-GacA two-component signal transduction system. Antimicrob. Agents Chemother. 2012, 56, 36–43. [Google Scholar] [CrossRef]
- Denning, G.M.; Wollenweber, L.A.; Railsback, M.A.; Cox, C.D.; Stoll, L.L.; Britigan, B.E. Pseudomonas pyocyanin increases interleukin-8 expression by human airway epithelial cells. Infect. Immun. 1998, 66, 5777–5784. [Google Scholar] [CrossRef]
- Lauredo, I.T.; Sabater, J.R.; Ahmed, A.; Botvinnikova, Y.; Abraham, W.M. Mechanism of pyocyanin- and 1-hydroxyphenazine-induced lung neutrophilia in sheep airways. J. Appl. Physiol. 1998, 85, 2298–2304. [Google Scholar] [CrossRef]
- Britigan, B.E.; Rasmussen, G.T.; Cox, C.D. Augmentation of oxidant injury to human pulmonary epithelial cells by the Pseudomonas aeruginosa siderophore pyochelin. Infect. Immun. 1997, 65, 1071–1076. [Google Scholar] [CrossRef] [PubMed]
- Hassan, H.M.; Fridovich, I. Mechanism of the antibiotic action pyocyanine. J. Bacteriol. 1980, 141, 156–163. [Google Scholar] [CrossRef] [PubMed]
- Metzger, B.T.; Barnes, D.M.; Reed, J.D. Purple carrot (Daucus carota L.) polyacetylenes decrease lipopolysaccharide-induced expression of inflammatory proteins in macrophage and endothelial cells. J. Agric. Food Chem. 2008, 56, 3554–3560. [Google Scholar] [CrossRef] [PubMed]
- Becher, A.; Schweizer, H.P. Integration-proficient Pseudomonas aeruginosa vectors for isolation of single-copy chromosomal lacZ and lux gene fusions. Biotechniques 2000, 29, 948–952. [Google Scholar] [CrossRef]
- Simon, R.; Priefer, U.; Puhler, A. A broad host range mobilization system for in vivo genetic engineering: Transposon mutagenesis in gram negative bacteria. Nat. Biotech. 1983, 1, 784–791. [Google Scholar] [CrossRef]
- Fu, B.; Wu, Q.; Dang, M.; Bai, D.; Guo, Q.; Shen, L.; Duan, K. Inhibition of Pseudomonas aeruginosa Biofilm Formation by Traditional Chinese Medicinal Herb Herba patriniae. Biomed. Res. Int. 2017, 2017, 10. [Google Scholar] [CrossRef]
- Chugani, S.A.; Whiteley, M.; Lee, K.M.; D’Argenio, D.; Manoil, C.; Greenberg, E.P. QscR, a modulator of quorum-sensing signal synthesis and virulence in Pseudomonas aeruginosa. Proc. Natl. Acad. Sci. USA 2001, 98, 2752–2757. [Google Scholar] [CrossRef]
- Essar, D.W.; Eberly, L.; Hadero, A.; Crawford, I.P. Identification and characterization of genes for a second anthranilate synthase in Pseudomonas aeruginosa: Interchangeability of the two anthranilate synthases and evolutionary implications. J. Bacteriol. 1990, 172, 884–900. [Google Scholar] [CrossRef]
- Rashid, M.H.; Kornberg, A. Inorganic polyphosphate is needed for swimming, swarming, and twitching motilities of Pseudomonas aeruginosa. Proc. Natl. Acad. Sci. USA 2000, 97, 4885–4890. [Google Scholar] [CrossRef]

| Strains or Plasmids | Relevant Characteristics | Source or Reference |
|---|---|---|
| Strains | ||
| PAO1 | Wild-type | [26] |
| E. coli SM10-λpir | mobilizing strain, RP4 integrated in the chromosome; Knr | Invitrogen |
| CTX- fliG | Integration reporter strain, CTX6.1 with a fragment of pKD-fliG containing fliG promoter region and luxCDABE gene; Knr, Tmpr, Tcr | This study |
| CTX- fliC | Integration reporter strain, CTX6.1 with a fragment of pKD-fliC containing fliC promoter region and luxCDABE gene; Knr, Tmpr, Tcr | This study |
| CTX-phzA1 | Integration reporter strain, CTX6.1 with a fragment of pKD-phzA1 containing phzA1 promoter region and luxCDABE gene; Knr, Tmpr, Tcr | [23] |
| CTX-phzA2 | Integration reporter strain, CTX6.1 with a fragment of pKD-phzA2 containing phzA2 promoter region and luxCDABE gene; Knr, Tmpr, Tcr | [23] |
| CTX-exoS | Integration reporter strain, CTX6.1 with a fragment of pKD-exoS containing exoS promoter region and luxCDABE gene; Knr, Tmpr, Tcr | [23] |
| CTX-exoT | Integration reporter strain, CTX6.1 with a fragment of pKD-exoT containing exoT promoter region and luxCDABE gene; Knr, Tmpr, Tcr | [23] |
| CTX-exsD | Integration reporter strain, CTX6.1 with a fragment of pKD-exsD containing exsD promoter region and luxCDABE gene; Knr, Tmpr, Tcr | [25] |
| CTX-exsC | Integration reporter strain, CTX6.1 with a fragment of pKD-exsC containing exsC promoter region and luxCDABE gene; Knr, Tmpr, Tcr | [25] |
| CTX-lasI | Integration reporter strain, CTX6.1 with a fragment of pKD-lasI containing lasI promoter region and luxCDABE gene; Knr, Tmpr, Tcr | This study |
| CTX-lasB | Integration reporter strain, CTX6.1 with a fragment of pKD-lasB containing lasB promoter region and luxCDABE gene; Knr, Tmpr, Tcr | This study |
| CTX-lasR | Integration reporter strain, CTX6.1 with a fragment of pKD-lasR containing lasR promoter region and luxCDABE gene; Knr, Tmpr, Tcr | This study |
| CTX-rhlI | Integration reporter strain, CTX6.1 with a fragment of pKD-rhlI containing rhlI promoter region and luxCDABE gene; Knr, Tmpr, Tcr | This study |
| CTX-rhlR | Integration reporter strain, CTX6.1 with a fragment of pKD-rhlR containing rhlR promoter region and luxCDABE gene; Knr, Tmpr, Tcr | This study |
| CTX-aprA | Integration reporter strain, CTX6.1 with a fragment of pKD-aprA containing aprA promoter region and luxCDABE gene; Knr, Tmpr, Tcr | This study |
| Plasmids | ||
| pMS402 | Expression reporter plasmid carrying the promoterless luxCDABE gene; Knr, Tmpr | [22] |
| CTX6.1 | Integration plasmid origins of plasmid mini-CTX-lux; Tcr | [25] |
| pRK2013 | Broad-host-range helper vector; Tra+, Knr | [27] |
© 2020 by the authors. Licensee MDPI, Basel, Switzerland. This article is an open access article distributed under the terms and conditions of the Creative Commons Attribution (CC BY) license (http://creativecommons.org/licenses/by/4.0/).
Share and Cite
Zhang, P.; Wu, Q.; Chen, L.; Duan, K. Virulence-Inhibiting Herbal Compound Falcarindiol Significantly Reduced Mortality in Mice Infected with Pseudomonas aeruginosa. Antibiotics 2020, 9, 136. https://doi.org/10.3390/antibiotics9030136
Zhang P, Wu Q, Chen L, Duan K. Virulence-Inhibiting Herbal Compound Falcarindiol Significantly Reduced Mortality in Mice Infected with Pseudomonas aeruginosa. Antibiotics. 2020; 9(3):136. https://doi.org/10.3390/antibiotics9030136
Chicago/Turabian StyleZhang, Pansong, Qiaolian Wu, Lin Chen, and Kangmin Duan. 2020. "Virulence-Inhibiting Herbal Compound Falcarindiol Significantly Reduced Mortality in Mice Infected with Pseudomonas aeruginosa" Antibiotics 9, no. 3: 136. https://doi.org/10.3390/antibiotics9030136
APA StyleZhang, P., Wu, Q., Chen, L., & Duan, K. (2020). Virulence-Inhibiting Herbal Compound Falcarindiol Significantly Reduced Mortality in Mice Infected with Pseudomonas aeruginosa. Antibiotics, 9(3), 136. https://doi.org/10.3390/antibiotics9030136

